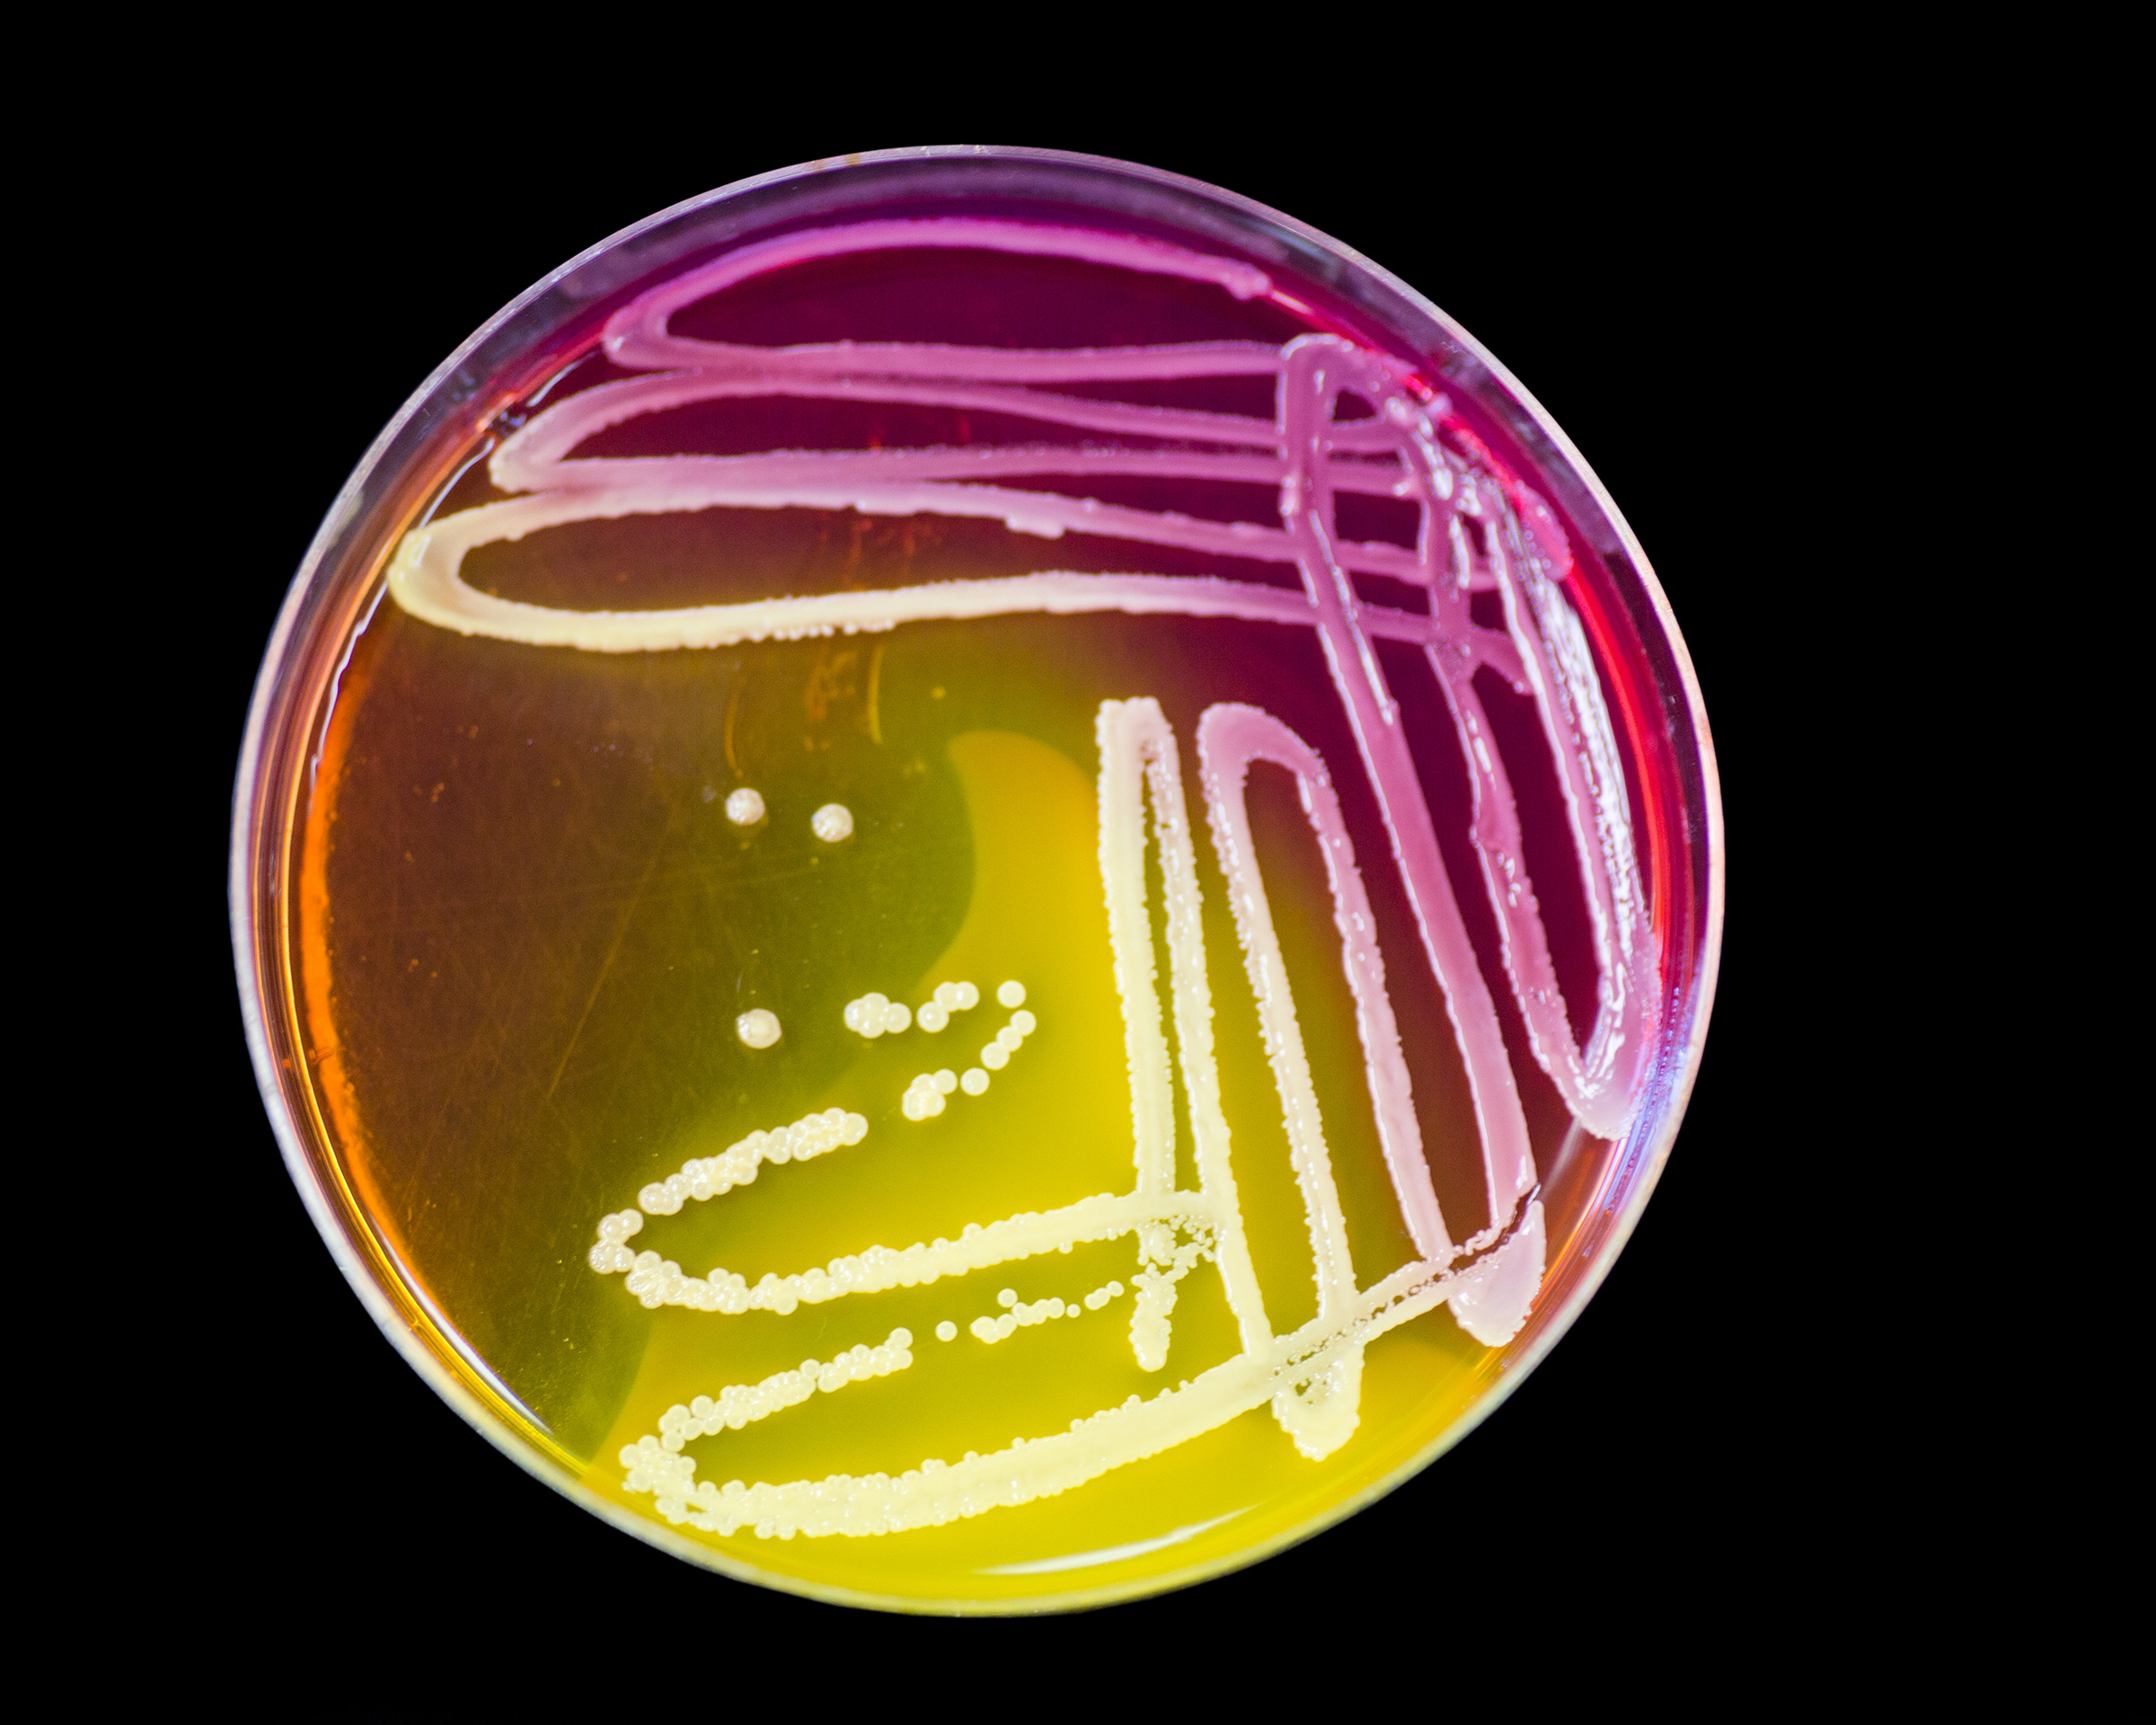

Determinando prazo de validade de alimentos preparados usando legislações
Certamente o assunto “prazo de validade” está no pódio dos campeões de dúvidas de clientes e potenciais clientes que buscam a consultoria em que sou


Certamente o assunto “prazo de validade” está no pódio dos campeões de dúvidas de clientes e potenciais clientes que buscam a consultoria em que sou
Muito frequentemente ouvimos que o limão cozinha peixes e frutos do mar em preparações como o ceviche, por exemplo. No entanto, essa definição está incorreta.
Aqui no Blog Food Safety Brazil postamos ao longo de 2020 várias matérias sobre a revogação da RDC 12 de 2001 de padrões microbiológicos para

No dia 24 de novembro de 2020 ocorreu virtualmente o IV Food Safety Brazil Meeting. O evento on-line, e não por isso menos rico, teve
Seja em casa, seja em um restaurante ou até mesmo ao pedir algo para beber em uma feira ou barraca de rua, você sabe avaliar

Essa é uma das perguntas campeãs quando participo de projetos de reforma ou construções de restaurantes e fábricas de alimentos. Aproveitando que foi também a

Esse é um assunto complicado, pois já perdi as contas de quantas vezes pessoas me procuraram buscando algum dos serviços de assessoria em segurança de

A Páscoa está chegando, junto com ela os maravilhosos ovos de Páscoa. Recebemos uma pergunta de uma de nossas leitoras sobre o tema: como fazer

Há alguns meses tenho notado o crescente uso de luvas pretas para manipulação de alimentos, especialmente em feiras gastronômicas, food trucks, hamburguerias e algumas redes

Atendendo ao pedido de nossos leitores, resolvi fazer um post com uma metodologia prática e divertida para saber se a barba está ou não na

Sabe aquele velho problema de restaurantes e cozinhas industriais? Que a luva de malha de aço é muito larga e por isso os funcionários acabam

A resposta para essa tão comum pergunta é: DEPENDE! Depende de quão quente o alimento está. Se você acabou de tirar o alimento da cocção,

Recebemos dos nossos leitores questionamentos sobre quando as unhas podem ou não ser consideradas compridas e por isso fiz esse post, para trazer uma dica para

Muitos de nossos leitores pediram nos comentários de alguns posts que fizéssemos um post com links de vídeos que podem ser usados em treinamentos de boas práticas

Independentemente do seu tamanho, todas as empresas de alimentos, bebidas, embalagens e ingredientes alimentícios devem ministrar treinamentos frequentes em Boas Práticas de Fabricação. Muitas vezes,

Nós do Blog Food Safety Brazil tivemos a oportunidade e o prazer de entrevistar a Presidente da Associação Prato Cheio, Dafna Kann, e conhecer um

Hoje compartilho com vocês leitores do Food Safety Brazil uma experiência pessoal. Faço parte de um grupo fechado em uma rede social dos moradores dos
Se você é da Cidade de São Paulo (SP), o nome da Licença Sanitária no município é outro: CMVS – Cadastro Municipal de Vigilância Sanitária.

Resolvi escrever esse post simples mas muito importante para conscientizar todos nós que cozinhamos em nossas casas. Muitos cometem erros sem que ao menos saibam

Em tempos de crise muitas pessoas buscam um plano B, seja ele um complemento da renda ou uma grande mudança na carreira, começar do zero.

As festas de final de ano estão se aproximando, e com elas, a comilança! Quem não adora a maionese que só aquela tia sabe fazer,

Cada vez mais empresas têm se deparado com esse dilema… Seja em atendimento requisito da ISO 22000 e da FSSC 22000 “Prontidão e respostas a

Você sabe quando o uso de LUVAS DESCARTÁVEIS É OBRIGATÓRIO PARA A MANIPULAÇÃO DE ALIMENTOS? Pois errou quem pensou que é sempre! Muito pelo contrário! Se

Quem trabalha em cozinhas comerciais e industriais e também em empresas que têm como matérias-primas legumes, vegetais e frutas in natura têm de lidar com